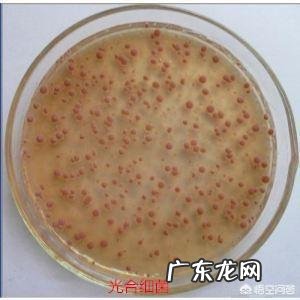
虾池解毒能和培菌培藻一起吗

虾塘用什么菌种肥水效果最好【虾池解毒能和培菌培藻一起吗】首先感谢你的邀请来回答你的问题,实际上每种有益菌在我们龙虾养殖过程中,都起到不同的作用,没有那种菌种肥水效果最好这样的说法,现在普遍流行的菌种使用方法是多种有益菌配合使用,起到互利互补的作用,下面给你简单的介绍几种我们龙虾养殖过程中常见的有益菌以及在养殖过程中所起到的作用 。
文章插图
一、光合细菌在虾塘中可以起到

文章插图
1、有效降解龙虾池塘里氨氮以及亚硝酸盐的含量,起到净化水质的作用,同时可以抑制有害藻类的滋生和生长 。

文章插图
2、可以提高小龙虾的免疫能力 。

文章插图
3、当池塘里有光合细菌的时候,可以提高池塘水体的透明度,有利于浮游生物进行光合作用 。

文章插图
二、芽孢杆菌在虾塘中可以起到

文章插图
1、芽孢杆菌净水能力特别强,有水体清洁剂之称 。
2、芽孢杆菌可以抑制蓝藻、甲藻、裸藻等有害藻的滋生和生长 。
3、芽孢杆菌对老水、黑水等异常水的调节作用比较好 。
4、可以有效分解池塘底部的有机废物,维持一个良好的池塘底部环境 。
三、硝化细菌在虾塘中可以起到
1、硝化细菌可以有效的降解龙虾养殖池塘的亚硝酸盐 。
2、硝化细菌可以加速水体中有机废物的分解和氧化,减少龙虾池塘里各类有机废物的沉淀 。
3、硝化细菌可以有效的阻断弧菌和发光菌的营养来源,起到一个抑制有害菌的增长作用 。
四、EM菌在虾塘中可以起到
1、EM菌可以提高小龙虾的食欲,增加小龙虾饲料的利用率 。
2、EM菌可以提高小龙虾的免疫能力和身体抵抗力,使小龙虾可以健康生长,提高龙虾的产量 。
3、EM菌可以起到净化水体的作用,促进有机污染物的分解和氧化 。
以上四种是我们龙虾养殖过程中常见的几种有益菌种,实际上可供我们龙虾养殖使用的菌种还有很多,比如酵母菌、蛭弧菌、乳酸菌、丁酸乳杆菌等等 。如果你对这方面感兴趣,可以去花点功夫了解一下这一块,毕竟因为篇幅限制,不好进行过多的介绍,比如每种菌种在什么环境下使用效果比较好,使用时有哪些注意事项等等 。
如果你想了解更多关于龙虾养殖,欢迎点击作者头像,关注作者,获取联系方式,也可以直接搜索雪源龙虾,我们可以为你提供精品成虾,优质虾苗,全程养殖技术指导 。
特别声明:本站内容均来自网友提供或互联网,仅供参考,请勿用于商业和其他非法用途。如果侵犯了您的权益请与我们联系,我们将在24小时内删除。
